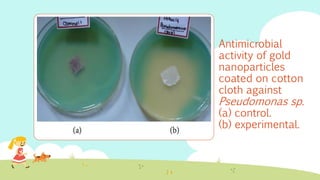
Antimicrobial
activity of gold
nanoparticles
coated on cotton
cloth against
Pseudomonas sp.
(a) control.
(b) experimental.

The document discusses the synthesis of nanoparticles using microorganisms such as bacteria and fungi. It describes intracellular and extracellular synthesis methods. Intracellular synthesis involves accumulation of nanoparticles inside the cell, while extracellular synthesis uses cell secretions outside the cell. Specific examples provided include gold and silver nanoparticles synthesized using bacteria and fungi through reduction of metal ions. The nanoparticles have a variety of shapes and sizes in the 1-100 nm range and potential applications.